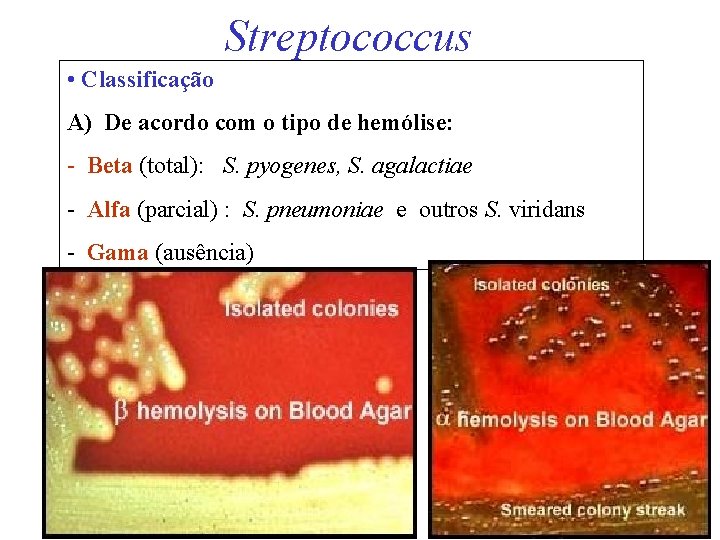
Streptococcus • Classificação A) De acordo com o tipo de hemólise: - Beta (total):
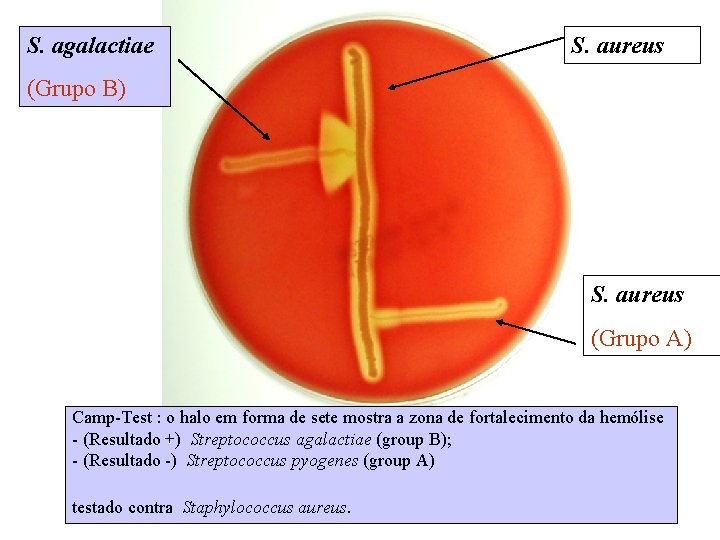
S. agalactiae S. aureus (Grupo B) S. aureus (Grupo A) Camp-Test : o halo
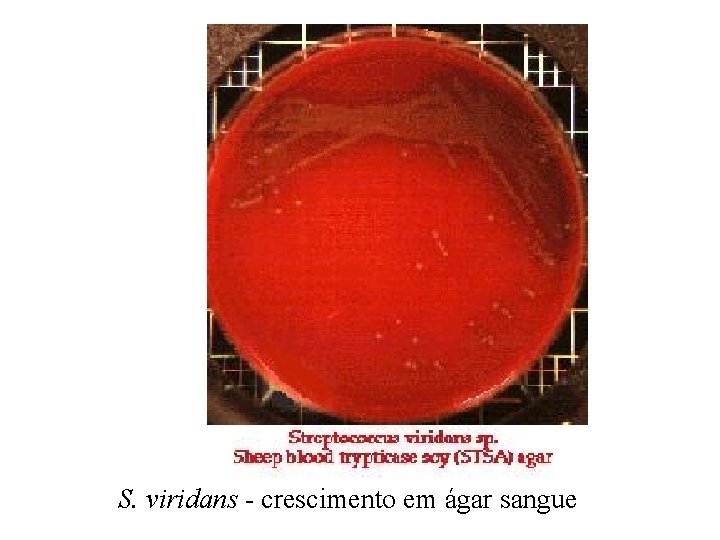
S. viridans - crescimento em ágar sangue

Streptococcus Planos da diviso celular Prova da catalase

- Slides: 49
Streptococcus
Planos da divisão celular
Prova da catalase Streptococcus são catalase negativa
Streptococcus
Streptococcus • Classificação A) De acordo com o tipo de hemólise: - Beta (total): S. pyogenes, S. agalactiae - Alfa (parcial) : S. pneumoniae e outros S. viridans - Gama (ausência)
B) Em 20 Grupos de SOROLÓGICOS, de acordo com o carboidrato C presente na superfície: (Grupos de Lancefield: De A até V) S. pneumoniae e S. viridans - Não são agrupáveis Rebbeca Lancefield
• Identificação: Sorológica Provas sorológicas do carbohidrato C
• Carboidrato C 20 grupos: De A até V Streptococcus - carboidratos de superfície
Streptococcus • Principais espécies: Beta hemolíticos: divididos em Grupos de SOROLÓGICOS (Grupos de Lancefield) S. pyogenes (Grupo A de Lancefield) - Bacitracina. S S. agalactiae (Grupo B de Lancefield) - Alfa hemolíticos: S. pneumoniae - Optoquina. S S. viridans - Gama : S. mutans S. pneumoniae e S. viridans - Não são agrupáveis pelo carboidrato C
Streptococcus pyogenes • Cocos Gram-positivos, • catalase negativos, • Beta hemolíticos, • do sorogrupo Grupo A (de Lancefield)
S. pyogenes - cultura e células coradas p/ Gram
S. pyogenes - aumento de 6. 500 x
S. pyogenes - aumento de 20. 000 x
S. pyogenes - aumento de 28. 000 (septo)
S. pyogenes - aumento de 70. 000
S. pyogenes - aumento de 70. 000
S. pyogenes - aumento de 78. 000 (fimbrias e início da divisão celular)
S. pyogenes - aumento de 96. 000
S. pyogenes - aumento de 96. 000
• Bacitracina S S. pyogenes • Identificação: Beta hemolítico + Sensibilidade a bacitracina = beta hemolítico do (soro)grupo A = S. pyogenes
S. pyogenes – Fatores de virulência - Cápsula - Proteína M - Proteína F - Hialuronidase - Estreptolisina S (sensível ao oxigênio) e O (insensível ao oxigênio) - DNases • Superantígeno - Exotoxinas pirogênicas
S. pyogenes - proteínas excretadas
Exotoxina pirogênica • a Exotoxina pirogênica (Spe) • Spe. A, Spe. B, Spe. C (SUPERANTÍGENOS) • IL-2 e outras citocinas: IL-1, IL-6, TNF, Interferon a • Falência orgânica.
S. pyogenes - cápsula
S. pyogenes - doenças
S. pyogenes - doença nas artérias
Streptococcus agalactiae • Cocos Gram-positivos, • catalase negativos, • Beta hemolíticos, • do sorogrupo B (de Lancefield)
S. agalactiae S. aureus (Grupo B) S. aureus (Grupo A) Camp-Test : o halo em forma de sete mostra a zona de fortalecimento da hemólise - (Resultado +) Streptococcus agalactiae (group B); - (Resultado -) Streptococcus pyogenes (group A) testado contra Staphylococcus aureus.
S. agalactiae - mastite
S. agalactiae - Doença Neonatal de Inicio Precoce Doença Neonatal de Início Tardio
Streptococcus • Classificação: De acordo com o tipo de hemólise: - Beta (total): divididos em Grupos de SOROLÓGICOS (Grupos de Lancefield) - S. pyogenes - S. agalactiae - Alfa (parcial) : - S. pneumoniae e outros S. viridans - Gama (ausência)
Streptococcus viridans
S. viridans - crescimento em ágar sangue
S. viridans - células coradas p/Gram
Streptococcus pneumoniae
S. pneumoniae (diplococos) corados p/ Gram
S. pneumoniae - bacterioscopia direta de catarro
S. pneumoniae - células com aumento de 20. 000 x
S. pneumoniae - Experiência pioneira de transformação genética de Griffith (1944)
S. pneumoniae - Células lisas, com cápsula (esquerda)) e rugosas, sem cápula (esquerda)
S. pneumoniae - estrutura celular
S. pneumoniae - pneumonia
S. pneumoniae - Resistência bacteriana
Streptococcus • Classificação De acordo com o tipo de hemólise: - Beta (total): divididos em 20 Grupos de SOROLÓGICOS (Grupos de Lancefield: De A até V) - Alfa (parcial) : S. pneumoniae e outros S. viridans - Gama (ausência)
Streptococcus mutans
S. mutans - cárie
S. mutans - células
S. mutans -E a evolução da cárie
S. mutans - vacina